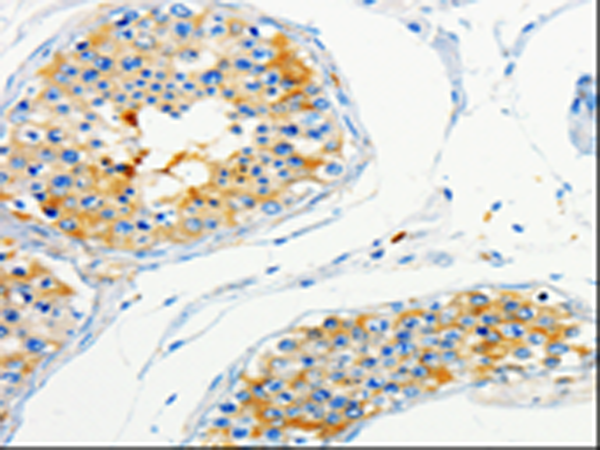

中文名稱:兔抗CAP1多克隆抗體
英文名稱: Anti-CAP1 rabbit polyclonal antibody
別 名: CAP, CAP1-PEN
抗 原: CAP1
儲(chǔ) 存: 冷凍(-20℃)
宿 主: Rabbit
相關(guān)類別: 一抗
反應(yīng)種屬: Human, Mouse, Rat
標(biāo) 記 物: Unconjugate
克隆類型: rabbit polyclonal
技術(shù)規(guī)格
|
Background: |
The protein encoded by this gene is related to the S. cerevisiae CAP protein, which is involved in the cyclic AMP pathway. The human protein is able to interact with other molecules of the same protein, as well as with CAP2 and actin. Alternatively spliced transcript variants have been identified. |
|
Applications: |
ELISA, WB, IHC |
|
Name of antibody: |
CAP1 |
|
Immunogen: |
Fusion protein of human CAP1 |
|
Full name: |
Adenylyl cyclase-associated protein 1 |
|
Synonyms: |
CAP, CAP1-PEN |
|
SwissProt: |
Q01518 |
|
ELISA Recommended dilution: |
1000-5000 |
|
IHC positive control: |
Human skin |
|
IHC Recommend dilution: |
25-100 |
|
WB Predicted band size: |
52 kDa |
|
WB Positive control: |
Hela and HepG2 cells |
|
WB Recommended dilution: |
200-1000 |

購(gòu)物車(chē)
幫助
021-54845833/15800441009
